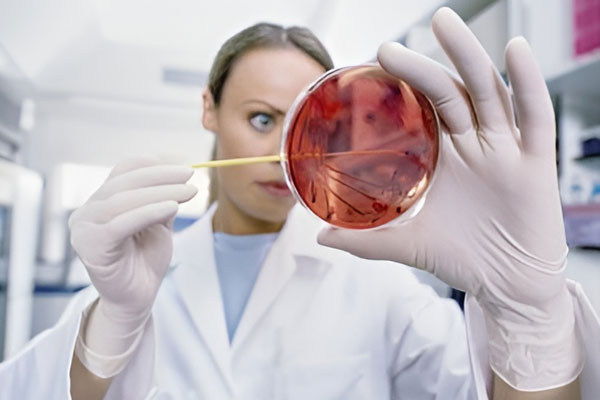

Plötzliche Hygieneverstöße, behördliche Beanstandungen oder Infektionsausbrüche können schnell zur Betriebsunterbrechung führen. In solchen Fällen ist rasches, professionelles Handeln gefragt. Wir entwickeln mit Ihnen betriebsspezifische Notfall- und Krisenpläne, die im Ernstfall klare Abläufe sichern und Schäden begrenzen.
Darüber hinaus stehen wir Ihnen auch bei akuten Hygienenotfällen zur Seite: Wir analysieren die Lage vor Ort, leiten Sofortmaßnahmen ein und unterstützen Sie ggf. auch bei der Kommunikation mit Behörden. Unser Ziel ist es, Ihre Betriebsfähigkeit schnellstmöglich wiederherzustellen – mit minimalem Aufwand für Sie und Ihre Mitarbeiter.